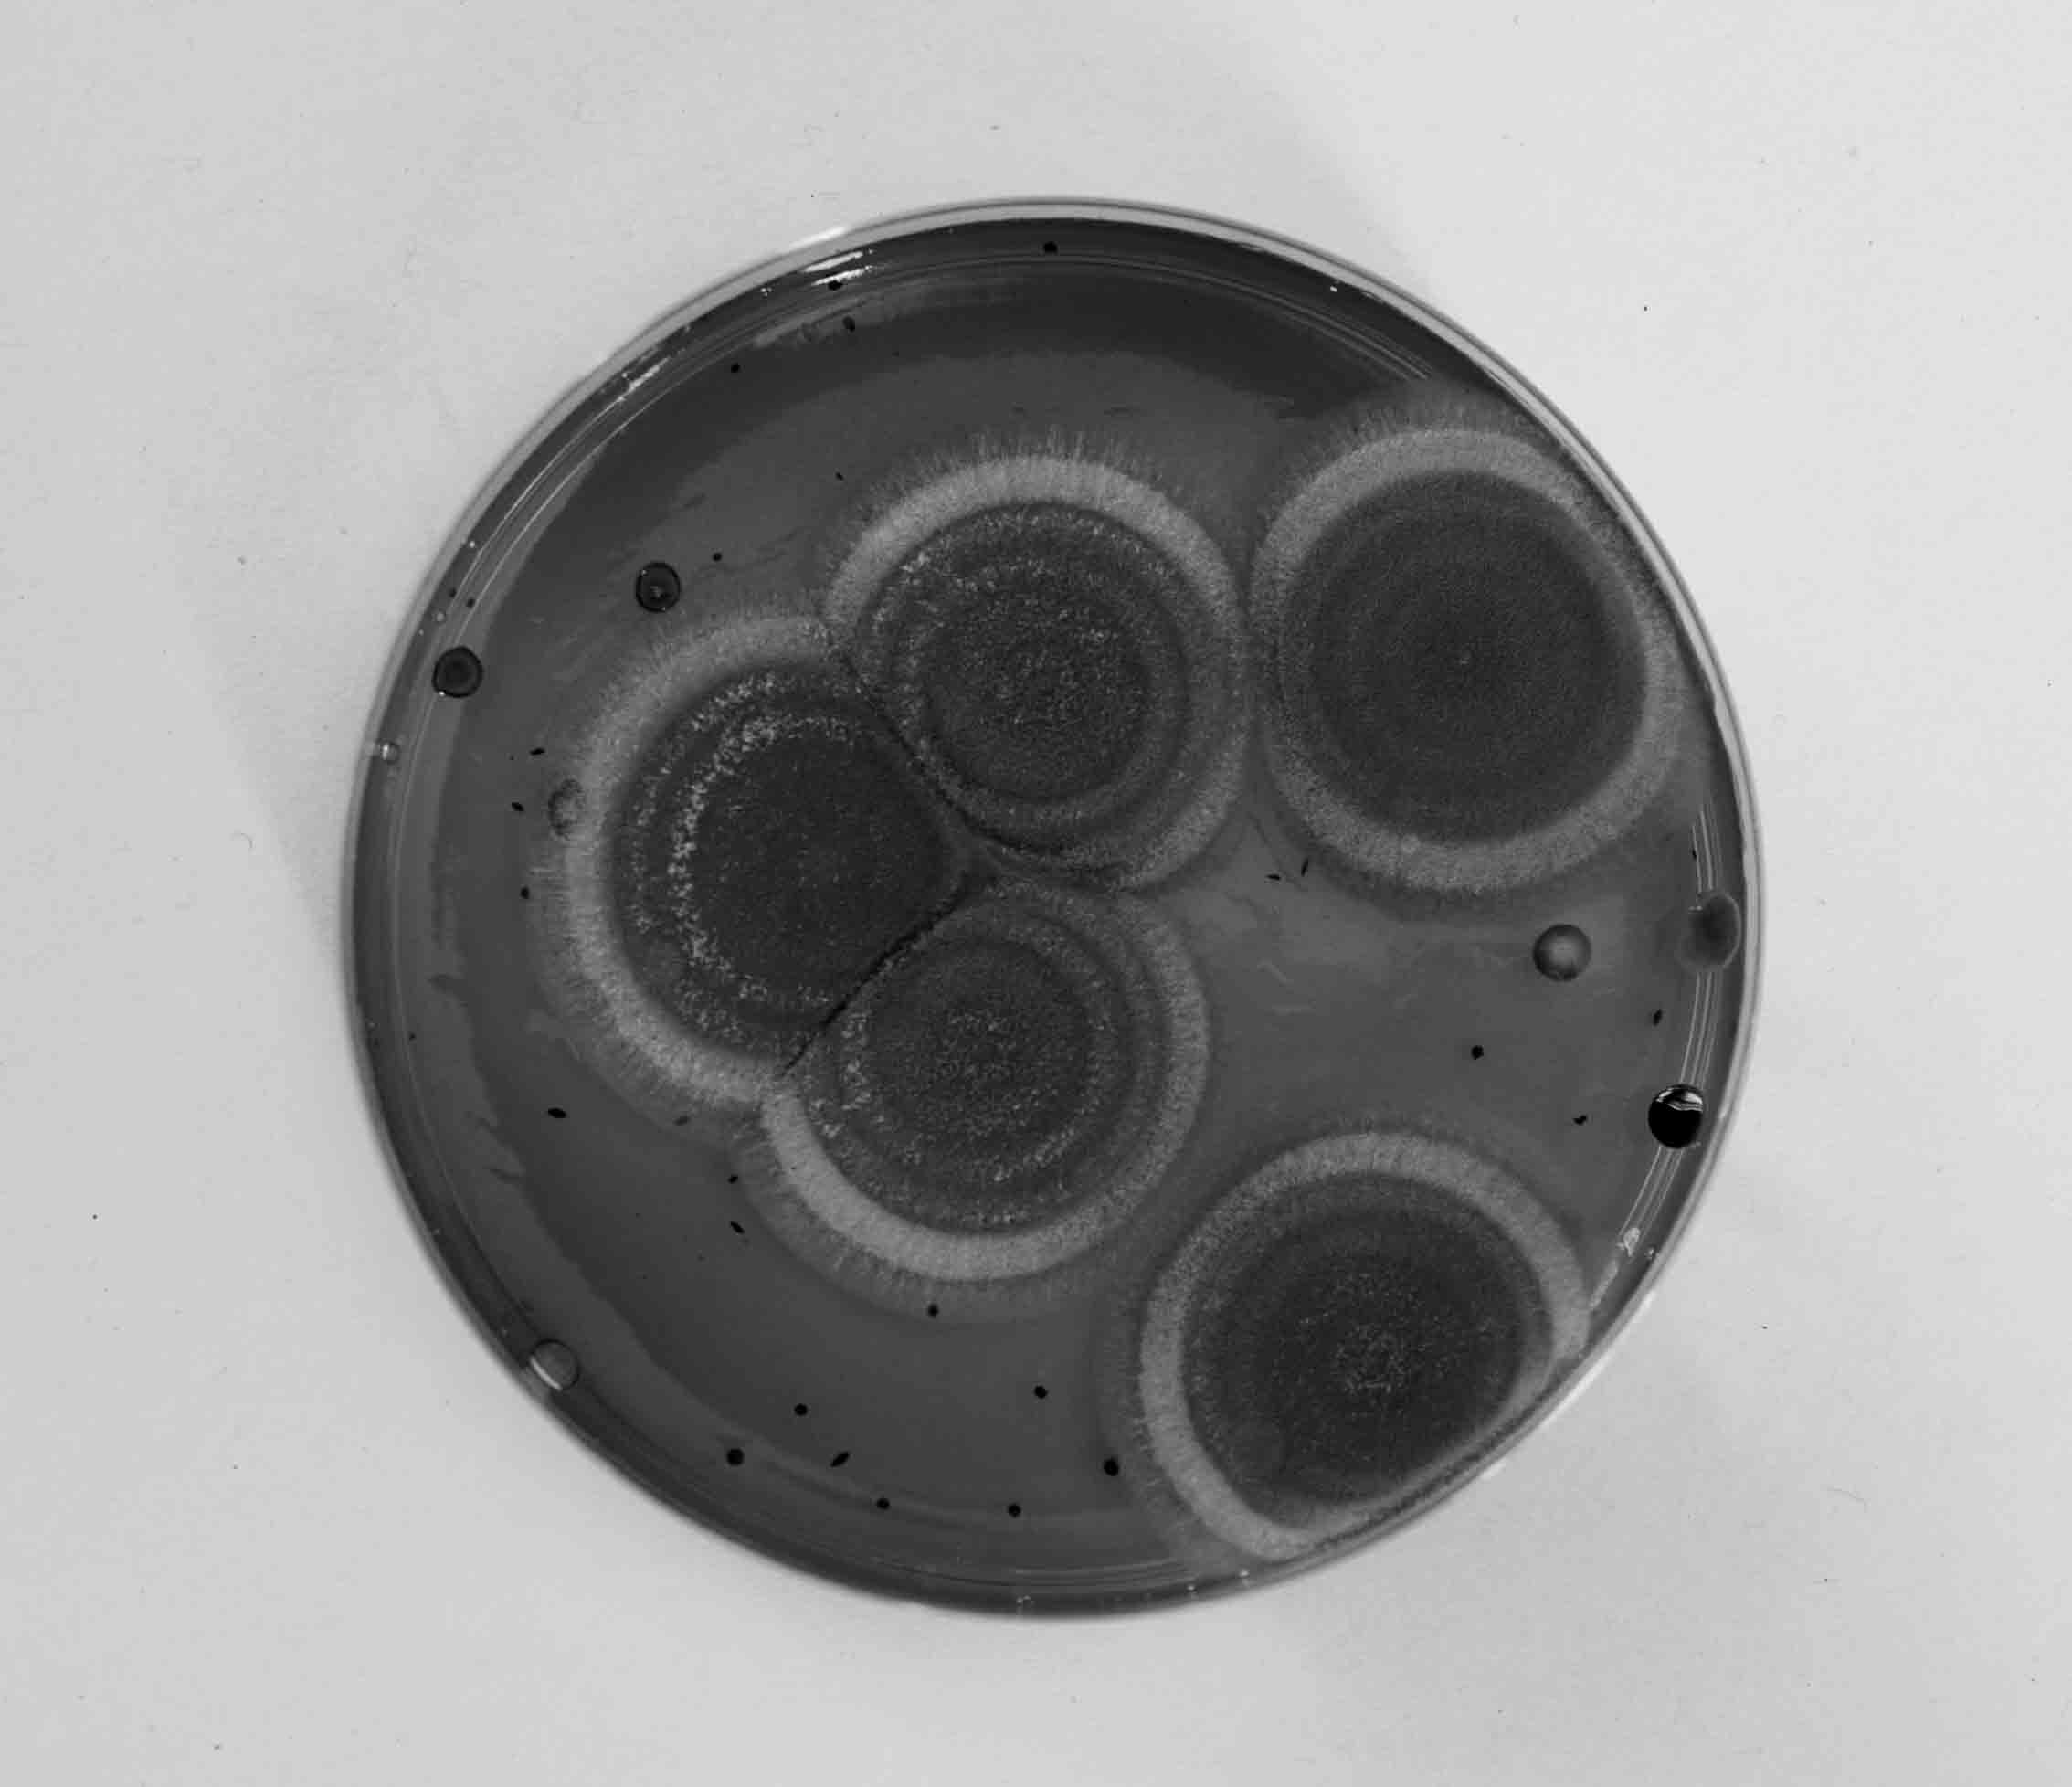
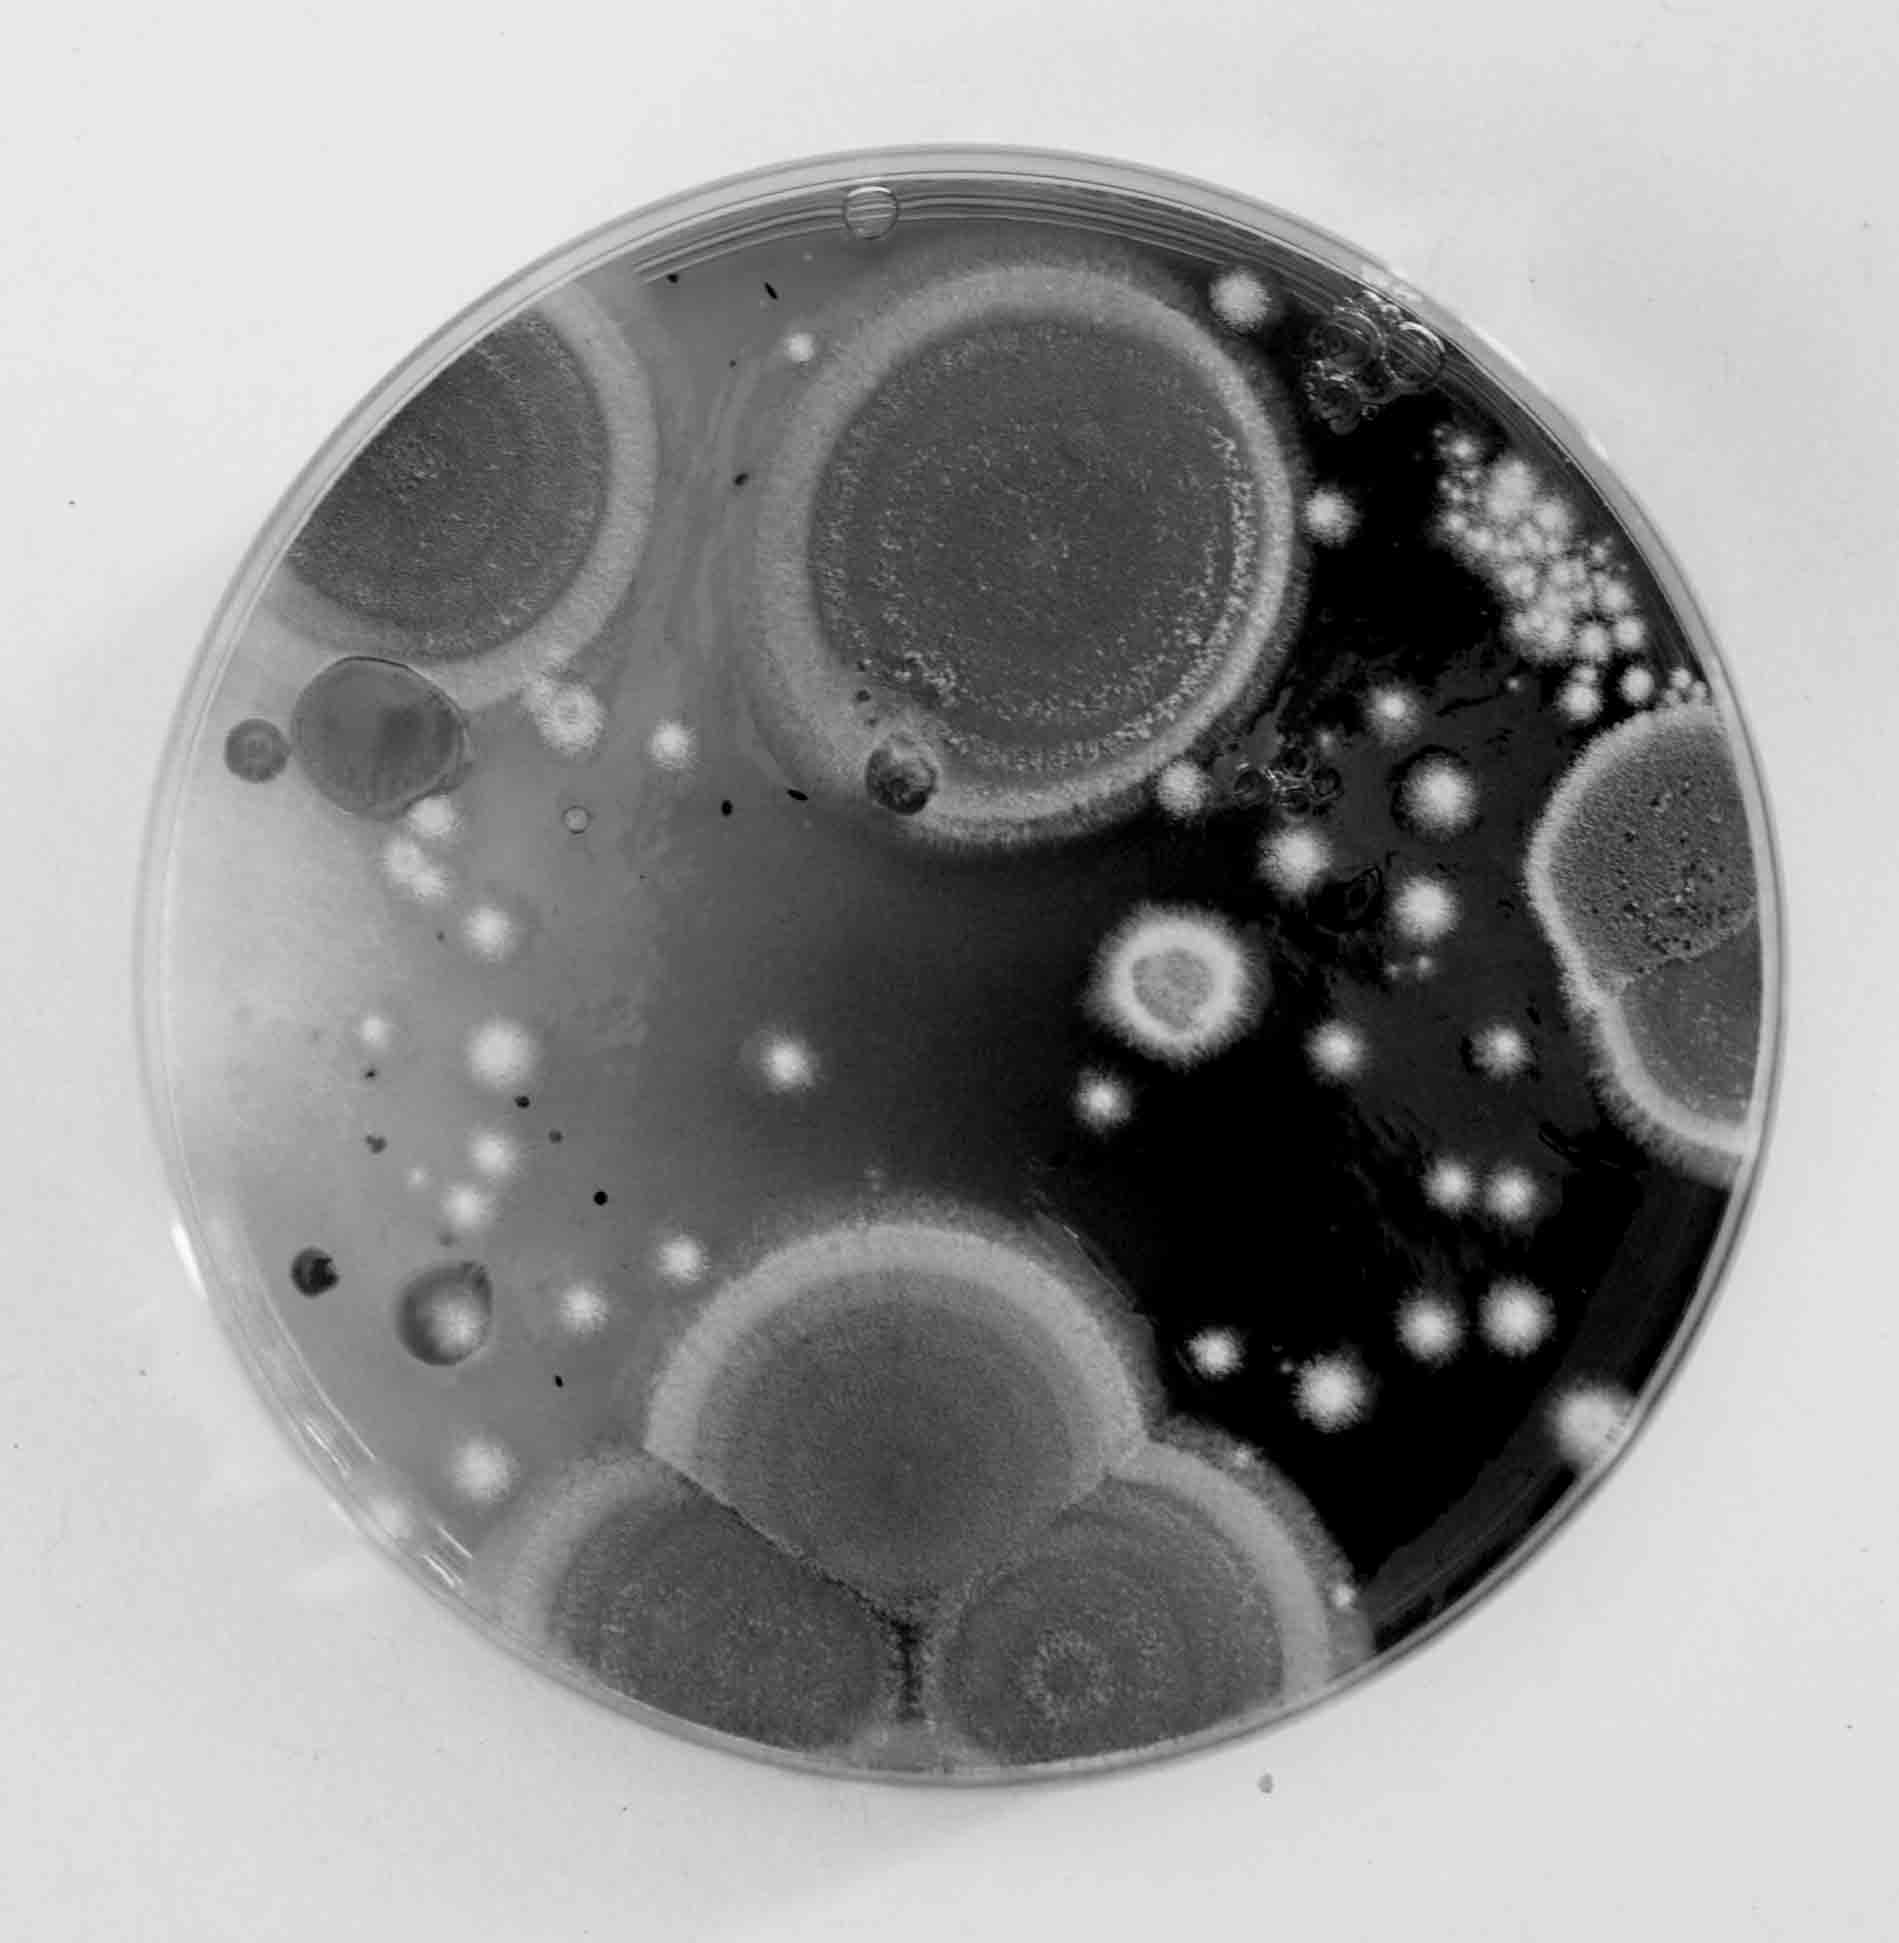

Myco-Landscape
Part I
2019
20x20 cm
Série de macrophotographies noir et blanc.
Boites de pétri, culture de bactéries, levures et champignons.
Prix par mail

Myco-Landscape
Part II
2019
30x20 cm
Série de macrophotographies noir et blanc.
Boites de pétri, culture de bactéries, levures et champignons
Prix par mail




